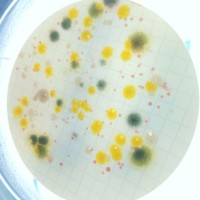
Mourad Benamor
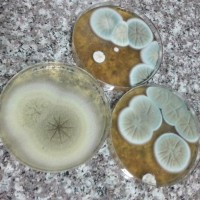
Meryem Bouzentouta

Company Details
- Employees
- 20
- Founded
- 2018
- Address
- Zone Industrielle Ouled Salah, Jijel,algeria
- Industry
- Pharmaceutical Manufacturing
- NAICS
-
Pharmaceutical and Medicine ManufacturingMedicinal and Botanical ManufacturingPharmaceutical Preparation ManufacturingIn-Vitro Diagnostic Substance ManufacturingBiological Product (except Diagnostic) Manufacturing
- HQ
- Jijel